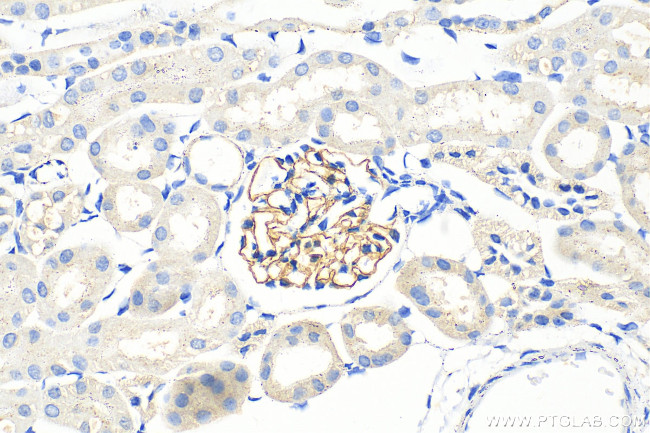
Nephrin Antibody in Immunohistochemistry (Paraffin) (IHC (P))

Search
Proteintech
Nephrin Polyclonal Antibody
{{$productOrderCtrl.translations['antibody.pdp.commerceCard.promotion.promotions']}}
{{$productOrderCtrl.translations['antibody.pdp.commerceCard.promotion.viewpromo']}}
{{$productOrderCtrl.translations['antibody.pdp.commerceCard.promotion.promocode']}}: {{promo.promoCode}} {{promo.promoTitle}} {{promo.promoDescription}}. {{$productOrderCtrl.translations['antibody.pdp.commerceCard.promotion.learnmore']}}
产品信息
22912-1-AP
种属反应
已发表种属
宿主/亚型
分类
类型
抗原
偶联物
形式
浓度
规格
纯化类型
保存液
内含物
保存条件
运输条件
产品详细信息
Immunogen sequence: PARGEFHLHI EACDLSDDAE YECQVGRSEM GPELVSPRVI LSILVPPKLL LLTPEAGTMV TWVAGQEYVV NCVSGDAKPA PDITILLSGQ TISDISANVN EGSQQKLFTV EATARVTPRS SDNRQLLVCE ASSPALEAPI KASFTVNVLF PPGPPVIEWP GLDEGHVRAG QSLELPCVAR GGNPLATLQW LKNGQPVSTA WGTEHTQAVA RSVLVMTVRP EDHGAQLSCE AHNSVSAGTQ EHGITLQVTF PPSAIIILGS ASQTENKNVT LSCVSKSSRP RVLLRW
靶标信息
Primary steroid resistant nephrotic syndrome (SRNS) is characterized by childhood onset of proteinuria and progression to end stage renal disease. Kidney podocytes and their slit diaphragms form the final barrier to urinary protein loss. Congenital nephrotic syndrome (CNS) is caused by mutations in NPHS1 (nephrin) or NPHS2. Nephrin, a recently identified protein is a member of a group of podocyte proteins that constitute major component of the slit diaphragm especially in the foot process. Nephrin, a cell adhesion molecule, may play a crucial role in maintaining the glomerular filtration barrier. Recent studies have suggested that mutations in the gene for Nephrin reportedly lead to congenital nephrosis. Three novel podocyte proteins, Podocin, Nephrin and alpha Actinin 4 have been identified in congenital and experimental models of proteinuria. The role of Nephrin in anti apoptotic activity in podocyte slit diaphragm is believed to be associated with vascular endothelial derived growth factors VEGF signaling. Nephrin seems to play a role in the development or function of the kidney glomerular filtration barrier and it may anchor the podocyte slit diaphragm to the actin cytoskeleton.
仅用于科研。不用于诊断过程。未经明确授权不得转售。
生物信息学
蛋白别名: Adhesion molecule nephrin; Nephrin; nephrin 1; nephrosis 1 homolog, nephrin; nephrosis 1, congenital, Finnish type (nephrin); NPHS1; NPHS1, nephrin; Protein nephrosis 1; Renal glomerulus-specific cell adhesion receptor
基因别名: CNF; nephrin; NephrinB; NPHN; NPHS1
UniProt ID: (Human) O60500, (Rat) Q9R044, (Mouse) Q9QZS7
Entrez Gene ID: (Human) 4868, (Rat) 64563, (Mouse) 54631